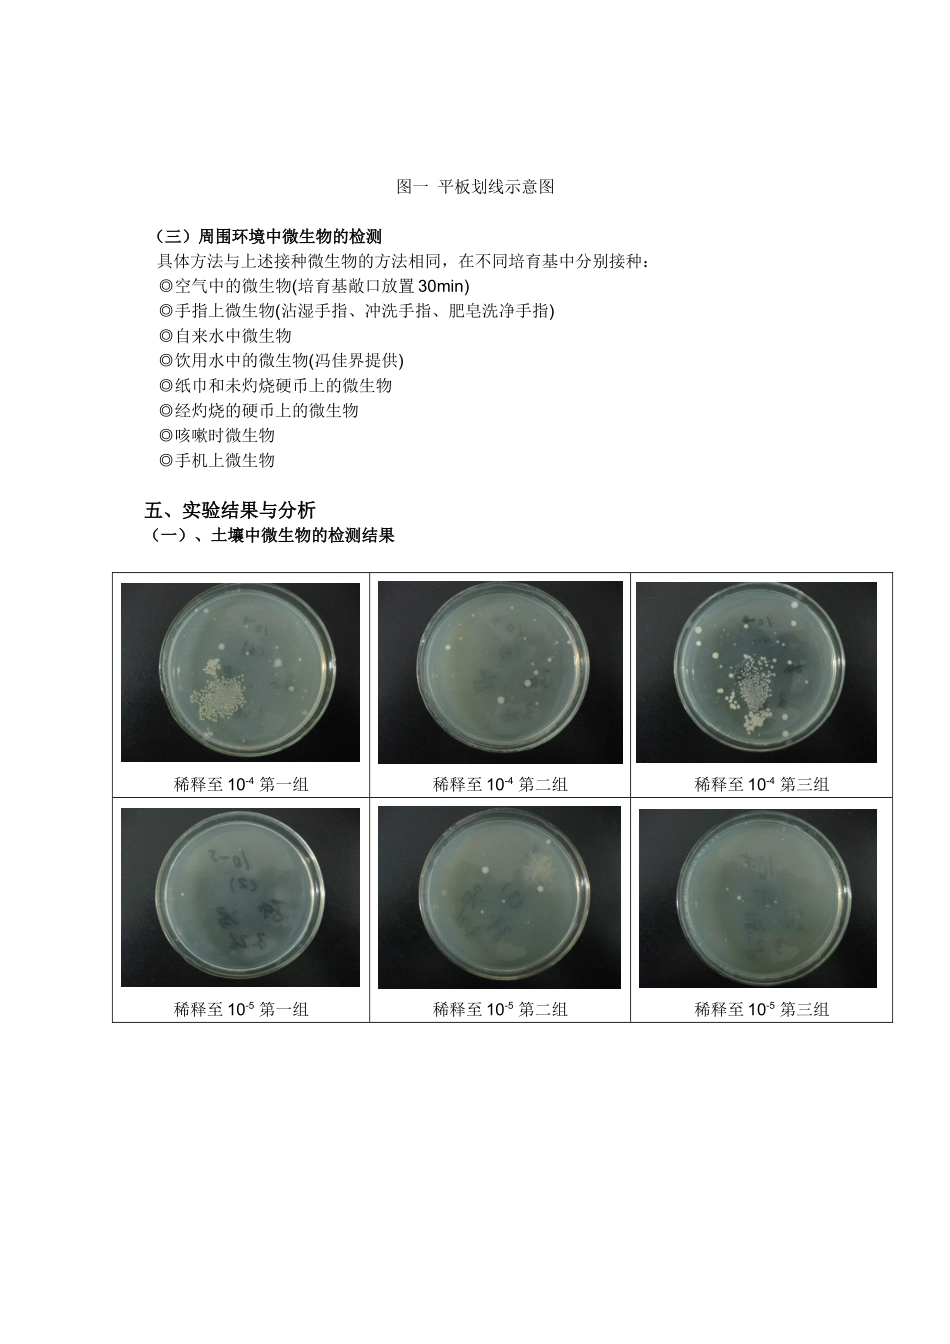
周围环境中微生物观察及分离实验_第3页

周围环境中微生物观察及分离实验生命科学学院 生 02 孙禹 2025012376实验日期:2025-3-26 同组姓名:张宇成、冯佳界一、实验目的1、熟悉常用微生物培育基的配制方法和原理2、学习并掌握各种无菌操作技术,并用此技术进行微生物稀释分离、划线分离接种3、用平板划线法和稀释法分离微生物4、认识微生物存在的普遍性,理解无菌操作原理二、实验原理 1、微生物的分离与纯化 从混杂的微生物群体中获得只含有某一种或某一株微生物的过程称为微生物的分离与纯化,常用的是平板分离法
为了获得某种微生物的纯培育,一般是根据该微生物对营养、酸碱度、温度和氧等条件要求不同,而供给它适宜条件的培育条件,或加入某些抑制剂造成抑制其他菌生长的环境,从而淘汰其他一些不需要的微生物
再用稀释涂布平板法或稀释后平板划线分离,纯化该微生物,直至得到纯菌株
通过这种方法可以获得很多有价值的菌株
2、平板菌落计数法 平板菌落计数法是将待测样品经适当稀释,使其中的微生物充分分散成单个细胞,取一定量的稀释样液接种到平板上,经过培育,由每个单细胞生长繁殖而形成肉眼可见的菌落即一个单菌落应代表原样品中的一个单细胞
统计菌落数,根据其稀释倍数和取样接种量即可换算出样品含菌数
这一统计方法可以获得活菌的信息,被广泛应用与生物制品检测中
三、实验仪器、材料和用具实验仪器和用具: 培育箱、接种环、酒精灯、打火机、平皿、涂棒、取液器(200ul、1000ul)、试管架、锥形瓶、EP 管若干、记号笔实验材料和试剂:土样 10g、大肠杆菌(用于平板划线)、无菌水、牛肉膏蛋白胨培育基每小组 20 个四、实验步骤 (一)、土壤中微生物的检测1、牛肉蛋白胨培育基的配制(琼脂为 2%)(已于上节课完成) 根据本组所需(共 6 人),按下面配方称量试剂:牛肉膏6g蛋白胨6g氯化钠12g蒸馏水1200ml表一 牛肉蛋白胨培育基组成◎最后加